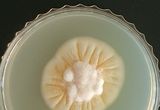

-

남양주시, 관내 주류제조업체와 손잡고 딸기맥주 협업 개발
- 2023-06-16 15:58
- 기자
-

해양수산부 , 광어·우럭회 등 양식수산물을 포함한 모든 수산물, 최대 반값 할인
- 2023-06-16 11:46
- 기자
-

산림청, 6월 이달의 임산물 ‘잣’
- 2023-06-16 10:28
- 기자
-

해양수산부, 인천지역 어시장 찾아 상인들과 소통
- 2023-06-15 20:54
- 기자
-

산림청, 송이 인공재배 기술 개발 눈앞에
- 2023-06-15 18:38
- 기자
-

해양수산부, “우리 바다의 수산물은 안전합니다” 유통업계·소비자와 소통 이어간다
- 2023-06-15 17:47
- 기자
-

전남도, 밥쌀용 벼 대체 작물 보급 확산
- 2023-06-15 17:32
- 기자
-

전남도, 천일염 안전·가격안정 머리 맞대
- 2023-06-15 17:28
- 기자
-

‘신안천일염’ 품귀 아니에요, 천천히 사세요!
- 2023-06-15 16:21
- 기자
-

부천문화원 향토음식 복원 프로젝트, 세계인이 주목하는 K-FOOD
- 2023-06-15 11:59
- 기자
-

토종 앉은키 밀로 만든 로컬 수제맥주‘진주진맥’인기!
- 2023-06-15 10:08
- 기자
-

식품의약품안전처, 달라지는 수입식품 안전 정책…궁금하다면 참여하세요!
- 2023-06-15 09:46
- 기자
-

농촌진흥청, 재래 닭 ‘오계’의 검은 피부색 비밀을 풀다
- 2023-06-15 09:40
- 기자
-

남해군 농산물종합가공센터‘가공품 선물세트’출시!
- 2023-06-15 09:29
- 기자
-

농림축산식품부 한국정책학회 정책대상 수상
- 2023-06-15 07:53
- 기자
-

전남도, 6월의 친환경농산물에 ‘유기농 밀’
- 2023-06-14 14:20
- 기자
-

포천시, '포천 강풍콩' 김구원선생두부에 납품 계약 성사
- 2023-06-14 13:04
- 기자
-

식품의약품안전처, 디지털 방식의 수입식품 전자심사…연내 가동
- 2023-06-14 11:34
- 기자
-

농촌진흥청, 장내 미생물로 ‘마’ 속 생리활성 물질 함량 늘린다
- 2023-06-14 11:26
- 기자
-

해양수산부, 올 여름, 해수욕장·수산물 안전하니 마음껏 이용하세요!
- 2023-06-13 18:38
- 기자
-

농촌진흥청, 온실 재배 열매채소, 약 뿌림 쉬워진다
- 2023-06-13 17:04
- 기자
-

농촌진흥청, ‘뒤영벌’ 꿀벌 빈자리 메워 딸기 생산 도왔다
- 2023-06-13 17:02
- 기자
-

경기도 농기원, ‘제1회 강풍콩 요리경연대회’ 개최
- 2023-06-13 16:45
- 기자
-

경상남도농업기술원, ‘내 손으로 빚는 전통주 교육’ 성료
- 2023-06-13 11:22
- 기자
- 1 에이치알그룹(주) ‘HR Dream Car’의 첫 행보로 아동복지시설 방문
- 2 순천향대, 에이치알그룹(주) 신호룡 대표 초청 간담회 개최
- 3 [제66회 KPGA 선수권대회 WITH A-ONE CC] KPGA와 에이원CC, 8년째 함께 만들어 나가는 ‘KPGA 선수권대회’의 역사
- 4 쿠팡, 서브허브 관리할 위탁 도급사로 에이치알그룹(주) 선정
- 5 쿠팡, 국내 택배시장에 가져온 혁신과 우려
- 6 에이치알그룹(주), ‘쿠팡 퀵플렉스 협력업체의 날 행사’ 시상식서 로켓배송 부문 2관왕 영예
- 7 드림틴(Dream Teen) 노원 유나이티드 FC U-18 한국의 라 마시아를 꿈꾼다!
- 8 하나은행 어플리케이선 '하나원큐' 접속 장애... 이용자들 불편
- 9 플로메디 김춘길 대표 “풀은 눕지만 꺾이지 않는다”
- 10 고흥군, 에이치알그룹(주)·(사)위드인사람과함께 장학금 전달